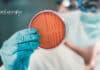
IIT Kanpur Antibiotic Resistance Project Recruitment – Assistant Vacancy IIT Kanpur Assistant Job

Autoantibodies That Attack ‘Self’ Tissues into Anti-Inflammatory Antibodies
Autoantibodies That Attack 'Self' Tissues into Anti-Inflammatory Antibodies
Autoantibodies are antibodies that react with self-antigens. These antigens may be found in all cell types (e.g....
Array BioPharma, Pfizer Strategic Tie-Up to Focus on Anti-Cancer Combos
Array BioPharma, Pfizer Strategic Tie-Up to Focus on Anti-Cancer Combos
Boulder-based Array BioPharma has now entered a strategic collaboration with Pfizer with intent to investigate...
Gene Therapy Using CAR-T Could Interfere With the Ability of HIV to Infect Cells
Gene Therapy Using CAR-T could Interfere With the Ability of HIV to Infect Cells
Antiviral drugs can suppress the amount of HIV in the body...
Five New Loci Associated with Asthma Found : Study
Five New Loci Associated with Asthma Found : Study
Asthma is a common lung condition that causes occasional breathing difficulties. It affects more than 300...
Blame your Bad Breath on This Gene – SELENBP1
Blame your Bad Breath on This Gene - SELENBP1
It’s a mortifying problem for millions. Bad breath, or halitosis, is one of the great unmentionables, despite...
Blood DNA Methylation Markers Detect Fatal Breast Cancer Up To a Year Earlier
Blood DNA Methylation Markers Detect Fatal Breast Cancer Up To a Year Earlier
Breast cancer is by far the most frequently occurring cancer in women....
The Chinese Successfully Clone a Canine in Bid to find Cure for Heart Disease
Chinese Successfully Clone a Canine in Bid to find Cure for Heart Disease
Earlier this year, experts at Sino Gene, a biotech company based in Beijing,...
Salamander’s Completely Sequenced Genome Throws Light on its Regenerative Capabilities
Salamander’s Completely Sequenced Genome Throws Light on its Regenerative Capabilities
Salamanders are such cool guys in addition to being mighty interesting, attributable to their regeneration...
Life Science Faculty, Lecturer & Professor Posts @ Biotecnika Chennai
Life Science Faculty, Lecturer & Professor Posts @ Biotecnika Chennai
BioTecNika Info Labs Pvt Ltd which runs India's Largest Biosciences Career & education Portal is...
Freshers Apply For BDO Post @ Biotecnika With Attractive Salary Package
Freshers Apply For BDO Post @ Biotecnika With Attractive Salary Package
BioTecNika Info Labs Pvt Ltd – Parent Company which runs India’s Largest Biosciences Career...
PhD Graduate Program @ The International Max Planck Research School
PhD Graduate Program @ The International Max Planck Research School
This call expires in :
The International Max Planck Research School for Heart and Lung Research...
Molecular Slasher: Dicer Proteins That Detect and Chop up a Viruses’ Genetic Material
Dicer Proteins That Detect and Chop up a Viruses’ Genetic Material
In humans, the vast majority of small regulatory RNAs are miRNAs. They have...
Amgen Scholars Program – 2018 @ Kyoto University & The University of Tokyo
Amgen Scholars - Japan Program | Undergraduate Summer Research Program
This call expires in :
Discover your potential
An undergraduate summer research program in science and biotechnology
Every...
Roche to Acquire Ignyta for $1.7B in a Bid to Bolster its Oncology Portfolio
Roche to Acquire Ignyta for $1.7B in a Bid to Bolster its Oncology Portfolio
Swiss Pharmaceutical Giant Roche has now entered a definitive merger agreement...
Biotecnika Times – Newsletter 28.12.2017
Govt Research Fellow Vacancy @ Botanical Survey of India (BSI)
Suitable candidates can walk-in for an interview to work on a MoEF&CC sponsored Lead Garden...